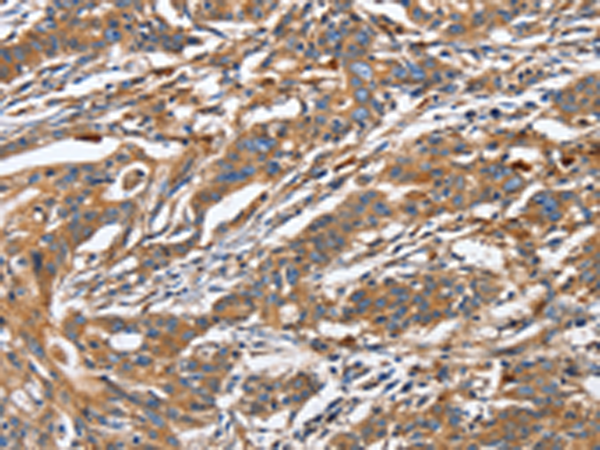
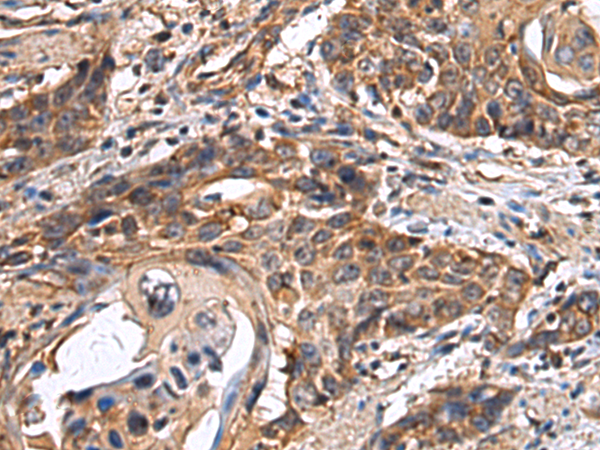
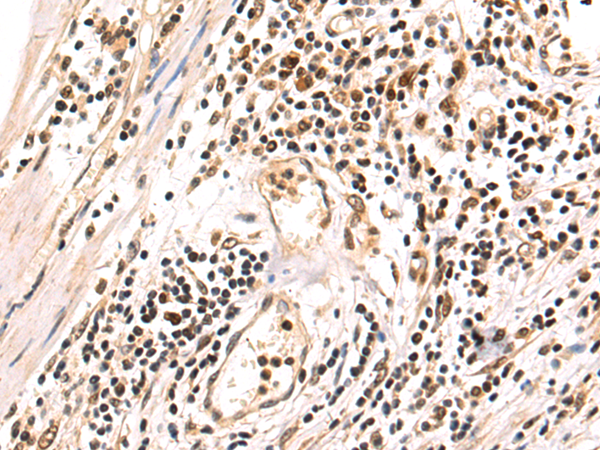
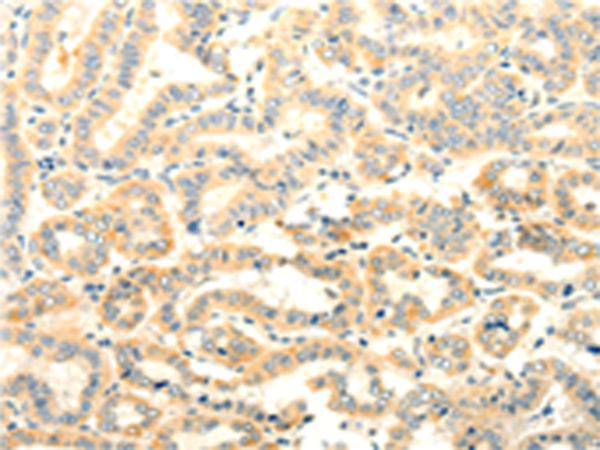

-
分类: 科研抗体货号: P00385别名: G13应用: WB,IHC反应种属: Human, Mouse, Rat
-
分类: 科研抗体货号: P00388别名: CR6, DDIT2, GRP17, GADD45gamma应用: IHC反应种属: Human, Mouse, Rat
-
分类: 科研抗体货号: P00428别名: HOX3I应用: WB反应种属: Human, Mouse
-
分类: 科研抗体货号: P00380别名: LGR1; ODG1; FSHR1; FSHRO应用: WB,IHC反应种属: Human, Mouse, Rat
-
分类: 科研抗体货号: P00425别名: HOX1, HOX1B, HOX1.2应用: IHC反应种属: Human, Mouse
-
分类: 科研抗体货号: P00378别名: ASD4应用: WB反应种属: Human, Mouse
-
分类: 科研抗体货号: P00424别名: HPA; HPA1; HPR1; HSE1; HPSE1应用: WB,IHC反应种属: Human, Rat
-
分类: 科研抗体货号: P00377别名: CPX; CLPA; TBXX; ABERS; dJ795G23.1应用: WB,IHC反应种属: Human
-
分类: 科研抗体货号: P00422别名: HO-1; HSP32; HMOX1D; bK286B10应用: IHC反应种属: Human, Mouse, Rat
-
分类: 科研抗体货号: P00376别名: FOXN6应用: WB,IHC反应种属: Human

鄂公网安备42018502007531号
鄂公网安备42018502007531号

